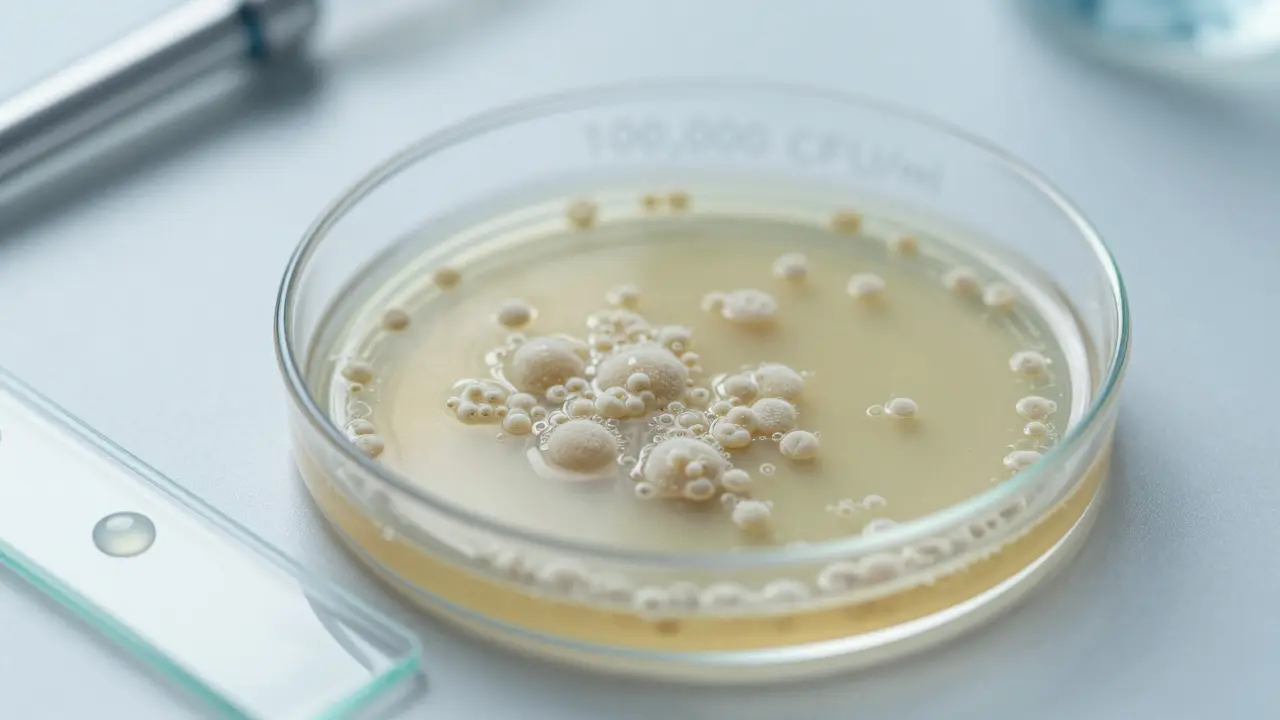
Jaké bakterie mohou být v moči a co to znamená pro vaše zdraví

Počítač pro posouzení rizika močové infekce
Tento nástroj pomáhá vyhodnotit riziko močové infekce na základě množství bakterií v moči a případných příznaků. Pamatujte, že konečná diagnóza musí být potvrzena lékařem.
Moč je čistá - alespoň tak to většina lidí předpokládá. Ale když se podíváte na výsledky laboratorního vyšetření, můžete najít něco, co vás překvapí: bakterie. Ne každá bakterie v moči je špatná. Některé tam prostě jsou, jiné znamenají, že je čas jít k lékaři. Co tedy skutečně znamená, když jsou v moči bakterie?
Co je normální a co je varovný signál?
U zdravého člověka by v moči měly být téměř žádné bakterie. Moč je vyráběna v ledvinách, prochází močovody a ukládá se v močovém měchýři - všechny tyto části jsou v normálním stavu sterilní. Když ale v analýze moči najdou lékaři nebo laboranti bakterie, neznamená to automaticky infekci. Někdy jde o kontaminaci - třeba z kůže, z anální oblasti nebo z vagíny, která se dostala do vzorku při sběru.
Pravá infekce se projevuje, když je počet bakterií v moči vyšší než 100 000 kolonií na mililitr (CFU/ml). To je standardní hranice, kterou používají laboratoře po celé České republice. Pokud je počet nižší, může to být náhodný zbytek. Pokud je vyšší, a zároveň máte příznaky jako pálení při močení, časté močení, bolest v břiše nebo zápach moče, je velmi pravděpodobné, že máte infekci močových cest.
Které bakterie se v moči nejčastěji objevují?
Nejčastější původce infekcí močových cest je Escherichia coli - zkráceně E. coli. Tato bakterie žije v našem střevě, kde je v pořádku. Ale když se dostane do močové trubice (uretry), může se cestou k močovému měchýři rozmnožit. Podle studií z Ústavu pro hygienu v Praze z roku 2024 způsobuje E. coli přes 80 % všech komunitních infekcí močových cest u dospělých žen.
Další časté původce jsou:
- Enterococcus faecalis - často se vyskytuje u starších lidí, u pacientů s kathetery nebo po operacích. Tato bakterie je odolnější a může být obtížnější léčit.
- Klebsiella pneumoniae - běžná v nemocnicích, může způsobit vážnější infekce, zejména u lidí s oslabenou imunitou.
- Proteus mirabilis - známá tím, že produkuje enzym, který mění pH moči a může vést ke vzniku kamenů v ledvinách.
- Staphylococcus saprophyticus - častý u mladých žen, obzvláště po začátku pohlavního života. Není spojen s hygienou, ale s anatomickými vlastnostmi.
- Pseudomonas aeruginosa - vyskytuje se hlavně u hospitalizovaných pacientů, u těch, kteří mají dlouhodobé katetry nebo po operacích močových cest.
U dětí, těhotných žen a starších lidí se mohou objevit i jiné druhy, ale většina případů stále padá na E. coli.
Proč se bakterie dostávají do moči?
Není to náhoda. Bakterie se do močových cest dostávají z jednoho místa - z okolí análního otvoru. U žen je močová trubice krátká a blízko anální oblasti, proto je infekce u nich častější. Stačí, když se po vyprázdnění střev nepřečistíte správně - od zadu dopředu - a bakterie se přenesou do uretry.
U mužů je riziko nižší, protože močová trubice je delší. Ale pokud má muž zvětšenou prostatu, kameny v močovém měchýři nebo používá katétr, může se infekce objevit i u něj. Těhotné ženy mají zvýšené riziko kvůli změnám v těle - tlak dělohy na močový měchýř, pomalejší odtok moče a změny hormonů, které usnadňují růst bakterií.
Nezapomínejte na další faktory: nesprávná hygiena, časté pohlavní styky, používání vaginálních sprejů nebo douch, a dokonce i nosení těsných spodního prádla z syntetických látek, které zadržují vlhkost - to vše vytváří ideální prostředí pro růst bakterií.

Co dělat, když najdou v moči bakterie?
Nikdy nezačínáte léčit sami. Pokud máte příznaky a výsledek ukazuje bakterie, lékař vám předepíše antibiotikum. Nejčastěji se používají:
- Fosfomycin - jednodenní léčba, vhodné pro jednoduché infekce
- Nitrofurantoin - účinný proti E. coli, ale nepoužívá se u pacientů s problémy s ledvinami
- Cefalosporiny - jako cefalexin, pokud je E. coli citlivá
- Trimethoprim/sulfamethoxazol - užívá se často, ale v posledních letech se v Česku zvyšuje odolnost E. coli proti tomuto léku
Je důležité, aby lékař nejen předepsal lék, ale i věděl, která bakterie je původcem. Proto se často dělá antibiogram - test, který ukazuje, která antibiotika danou bakterii zabijí. To je zásadní, aby se nelekaly antibiotika, která už neúčinkují.
Nežádoucí účinky? Můžou být - průjem, nevolnost, alergie. Ale největší riziko je neúplná léčba. Pokud přestanete užívat antibiotika, jakmile se cítíte lépe, bakterie se mohou přizpůsobit a stát se odolnými. A to může vést k opakujícím se infekcím, které jsou mnohem těžší léčit.
Když máte časté infekce - co dál?
Je-li infekce močových cest u vás nebo vaší dcery častá - třeba čtyřikrát za rok nebo více - je potřeba hlubší vyšetření. Někdy je příčinou anatomická vada, například zpětný tok moče z močového měchýře do ledvin. Někdy to může být diabetes, který oslabuje imunitu. Nebo může jít o postmenopauzální změny u žen - když klesá estrogenní hladina, sliznice močové trubice a pochvy se tenčí a stávají se křehčími.
V těchto případech lékař může doporučit:
- Provedení ultrazvuku ledvin a močového měchýře
- Testy na cukrovku
- Testy na hormony u žen po menopauze
- Dlouhodobou preventivní léčbu nízkými dávkami antibiotik
- Preventivní užívání D-mannózy - přirozeného cukru, který zabrání E. coli přilepení ke stěnám močového měchýře
Nezapomeňte na základní hygienické návyky: močte hned, když cítíte potřebu, nepoužívejte agresivní čisticí prostředky do pochvy, působte na tělo zpět - ne od zadu dopředu, a pijeťte dostatek vody. Dvě litry denně pomáhají vyplavovat bakterie předtím, než se začnou rozmnožovat.
Co o moči říkají laboratoře?
Když dostanete výsledek močového testu, hledejte tři věci:
- Počet kolonií (CFU/ml) - pokud je nad 100 000, je to podezřelé.
- Typ bakterie - E. coli? Enterococcus? To určuje, jak léčit.
- Antibiogram - která antibiotika fungují? To je klíč k úspěšné léčbě.
Někdy se výsledek objeví jako „mírný růst“ nebo „kontaminace“. To znamená, že bakterie tam jsou, ale nejsou v dostatečném množství, aby byly považovány za infekci. V takovém případě se nezačíná léčit - jen se sleduje. Pokud se příznaky nezmění, není třeba nic dělat.

Co se děje u dětí a těhotných žen?
U dětí je infekce močových cest častější než si většina rodičů myslí. U malých dětí se projevuje nejen bolestí, ale i horečkou bez jiných příznaků, nechutenstvím nebo neklidem. Pokud má dítě horečku a není jasné, proč, lékař vždy zkontroluje moč. Nezahájení léčby může vést k poškození ledvin.
U těhotných žen je infekce nebezpečná, protože může vést k předčasnému porodu. Proto se všechny těhotné ženy během prvního vyšetření podrobí standardnímu testu moči - i když se cítí dobře. Pokud jsou tam bakterie, léčí se ihned, i když žádné příznaky nejsou. To je prevence, ne reakce.
Co neudělat?
Nejčastější chyby, které lidé dělají:
- Přestanou užívat antibiotika, jakmile se cítí lépe
- Používají domácí prostředky - čaj z heřmánku, borůvky, nebo citron - jako jedinou léčbu
- Nezkontrolují, jestli mají cukrovku, která může infekci podporovat
- Nezajímají se o hygienické návyky
- Užívají antibiotika z předchozí infekce - bez předpisu a bez analýzy
Domácí prostředky jako borůvky nebo D-mannóza mohou pomoci jako doplněk, ale nikdy jako náhrada za lék. Bakterie nečekají, až si vyrobíte čaj. Pokud je infekce tam, potřebuje léčbu - rychle a správně.
Když jste zdraví, nezapomeňte na prevenci
Nejlepší léčba je ta, která se neobjeví. Aby se infekce neobjevila, stačí pár jednoduchých kroků:
- Pijte 1,5-2 litry vody denně
- Močte ihned, když cítíte potřebu - nečekáte
- Čistíte se od předu dozadu po močení
- Po pohlavním styku močte do 30 minut
- Nosíte bavlněné spodní prádlo
- Vyhněte se vaginálním sprejům a douchám
- Pokud máte časté infekce, zvažte D-mannózu jako doplněk stravy
Nejde o dokonalost. Jen o vědomost. Bakterie v moči nejsou zlo. Jsou přirozenou součástí našeho těla - ale jen tam, kde mají být. Když se dostanou tam, kde nepatří, potřebují pozornost. A ta je jednoduchá: vědět, co se děje, a nečekat, až se to zhorší.
Jsou všechny bakterie v moči špatné?
Ne. Malé množství bakterií může být výsledkem kontaminace při sběru vzorku - například z kůže nebo pochvy. Pravá infekce se diagnostikuje, když je počet bakterií vyšší než 100 000 kolonií na mililitr a zároveň jsou přítomny příznaky jako pálení při močení nebo bolest v břiše.
Je možné mít bakterie v moči bez příznaků?
Ano. Toto se nazývá asimptomatická bakteriurie. Je běžná u těhotných žen a starších lidí. U těhotných se léčí, protože může vést k předčasnému porodu. U ostatních se obvykle nelečí, pokud nejsou jiné rizikové faktory, jako například kathetr nebo transplantace ledviny.
Proč se E. coli objevuje v moči tak často?
E. coli žije v našem střevě a je velmi dobře přizpůsobená přežití v lidském těle. U žen je močová trubice krátká a blízko anální oblasti, takže se bakterie snadno přenášejí. Stovky studií potvrzují, že E. coli způsobuje více než 80 % infekcí močových cest u žen.
Mohu se infikovat pohlavním stykem?
Ano. Pohlavní styk může přenášet bakterie z oblasti pochvy nebo análního otvoru do močové trubice. Proto se doporučuje močit do 30 minut po styku, aby se bakterie vyplavily. Tento krok pomáhá předcházet infekcím, zejména u žen s častými problémy.
Je možné si vybrat antibiotikum sami?
Ne. Každá bakterie má jinou odolnost. Použití špatného antibiotika může zhoršit stav nebo způsobit odolnost. Lékař vždy nejprve zkontroluje typ bakterie a její citlivost na léky - to je základ správné léčby.